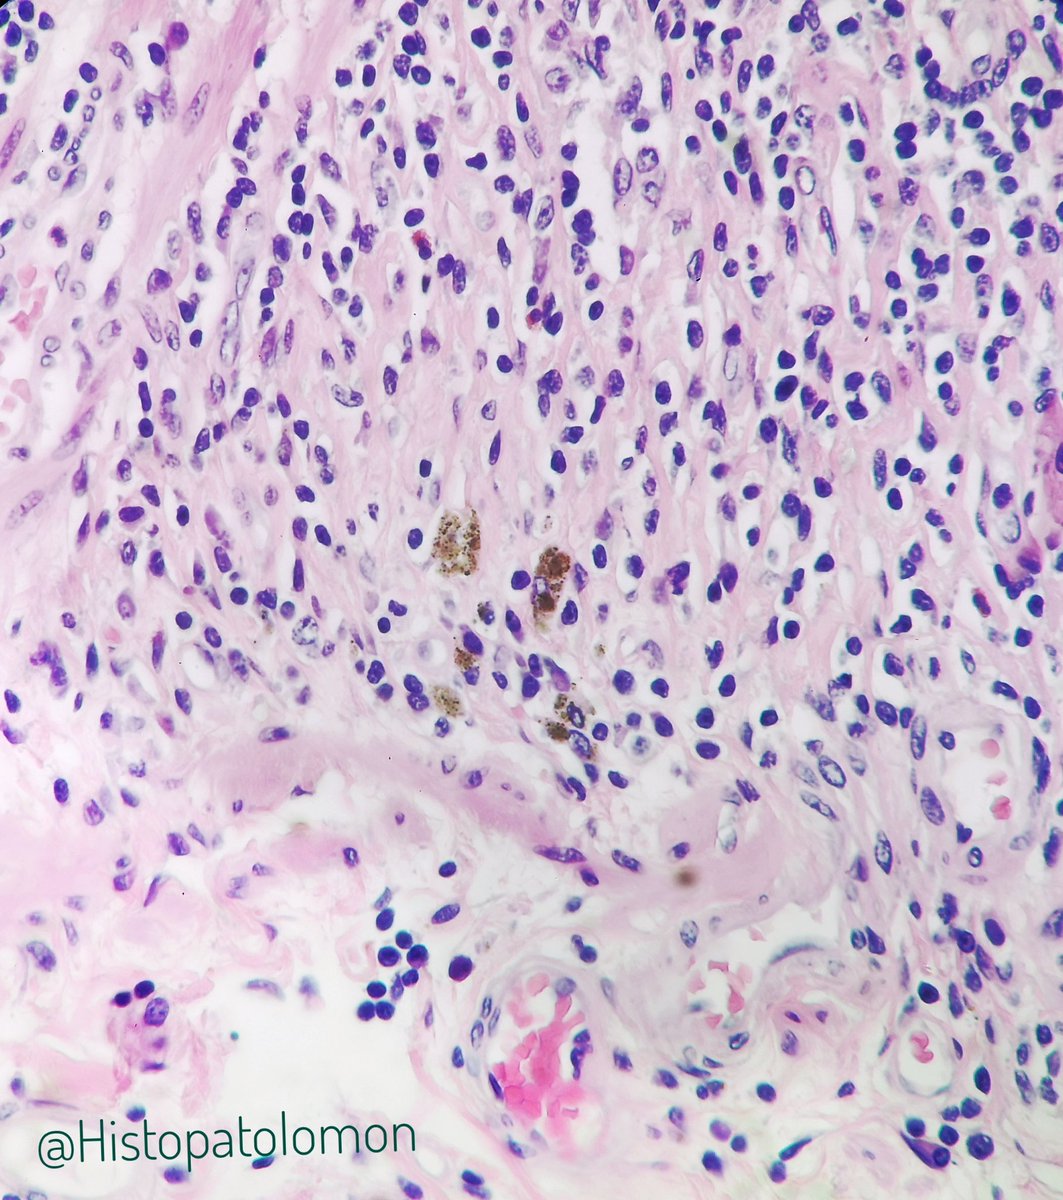
A characteristic of Peyer's patches in adults is the presence of macrophages with brown pigment at the base. It is known as titanium pigment, although in addition to Ti, aluminum, silicates and other substances have been found.Black Peyer's patches have been seen in coal miners.

If you see these mini-polyps in Ileon, what do you think they are? #pathology #GIpath #ileon #polyps @Alipathy @nucleololailo @DrPayelMondal @DraEosina @edusqo @steland011 @zucchiatti_ @gonzadetoro @pbaleixo @RunjanChetty @luishcruzc @ijexpafo @martiponi @DrGeeONE
They are solitary lymphoid follicles, they are absolutely normal, it is estimated that there are thousands in the intestine, more frequent in the terminal ileum, where they coexist with Peyer's patches. They are part of the GALT system. #GIpath #SolitaryLymphoidFollicles
Peyer's patches are clusters of these follicles. This is a Peyer's patch. Also seen an isolated follicle (red arrow). #GIpath #PatchofPeyer
Here we can see a Peyer's patch next to solitary follicles.
It is thought that the GALT system is the first defense system of vertebrates, which appeared, before other lymphoid organs, such as lymph nodes, the thymus spleen and bone marrow.
It is thought that the GALT system is the first defense system of vertebrates, which appeared, before other lymphoid organs, such as lymph nodes, the thymus spleen and bone marrow.
Johann Conrad Peyer, who worked alongside Johann Conrad Brunner, described these patches. Published in this book, where he also, curiously, describes the chicken gizzard.
This is the section of Peyer's patch shown earlier. Normally they are 2-3 cm, but they can reach 10 cm
A characteristic of Peyer's patches in adults is the presence of macrophages with brown pigment at the base. It is known as titanium pigment, although in addition to Ti, aluminum, silicates and other substances have been found.
Black Peyer's patches have been seen in coal miners.
Black Peyer's patches have been seen in coal miners.
These particles are introduced into the patches by the M cells, which, in addition to introducing the antigens, internalize these particles that come from food and atmospheric pollution, in a process that has been called persorption.
Titanium dioxide (TiO2) are nanoparticles used in the food industry to give a pure white color (nuclear white), used in more than 900 products, as additive (E171), also in whitening toothpastes, pills, sun creams, etc. France, for example, has proposed its ban.
Today a 13-week fetus arrived. I was curious if the Peyer's patches and Paneth's cells is already there. What do you think? Poll 

Will Peyer's patches and Paneth cells be in this intestine?
The correct official answer is: No, No
Isolated lymphoid follicles appear at 15-21 weeks and Peyer's patches at 25-29 weeks. As you can see, there is no muscularis mucosae (week 20) but there are goblet cells (week 7)
colon (orange), ileum (blue), appendix (black), valve (red)
Isolated lymphoid follicles appear at 15-21 weeks and Peyer's patches at 25-29 weeks. As you can see, there is no muscularis mucosae (week 20) but there are goblet cells (week 7)
colon (orange), ileum (blue), appendix (black), valve (red)
Neuroendocrine cells also appear at 7 weeks. Here we see them with their granules, next to the basement membrane.

 Read on Twitter
Read on Twitter